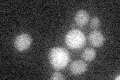
YKR028W
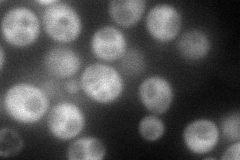
YKR028W
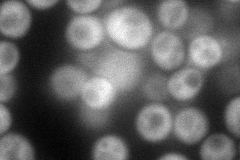
YKR028W
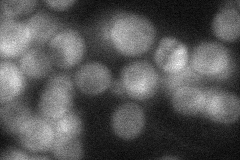
YKR028W
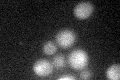
YKR028W
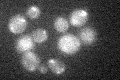
YKR028W

View description
Protein that forms a complex with the Sit4p protein phosphatase and is required for its function; member of a family of similar proteins including Sap4p, Sap155p, and Sap185p
Localization:
Intensity:
Fold change:
Significance:
-
C’ GFP library in SD
below threshold16.39 -
N' NOP1pr-GFP in SD
cytosol102.111 -
N' TEF2pr-mCherry in SD
cytosol109.759 -
N' NATIVEpr-GFP in SD
cytosol41.2068 -
N' TEF2pr-VC and Cyto-VN in SD

cytosol54.4711 -
C’ GFP library in SD+DTT
cytosol14.260.86No -
C’ GFP library in SD+H2O2
cytosol18.261.11No -
C’ GFP library in Starvation Media

cytosol16.681.01No -
C’ GFP library on the background of Pup2-DaMP

below threshold -
C’ GFP library on the background of CCT mutant

below threshold17.20541.04876No
